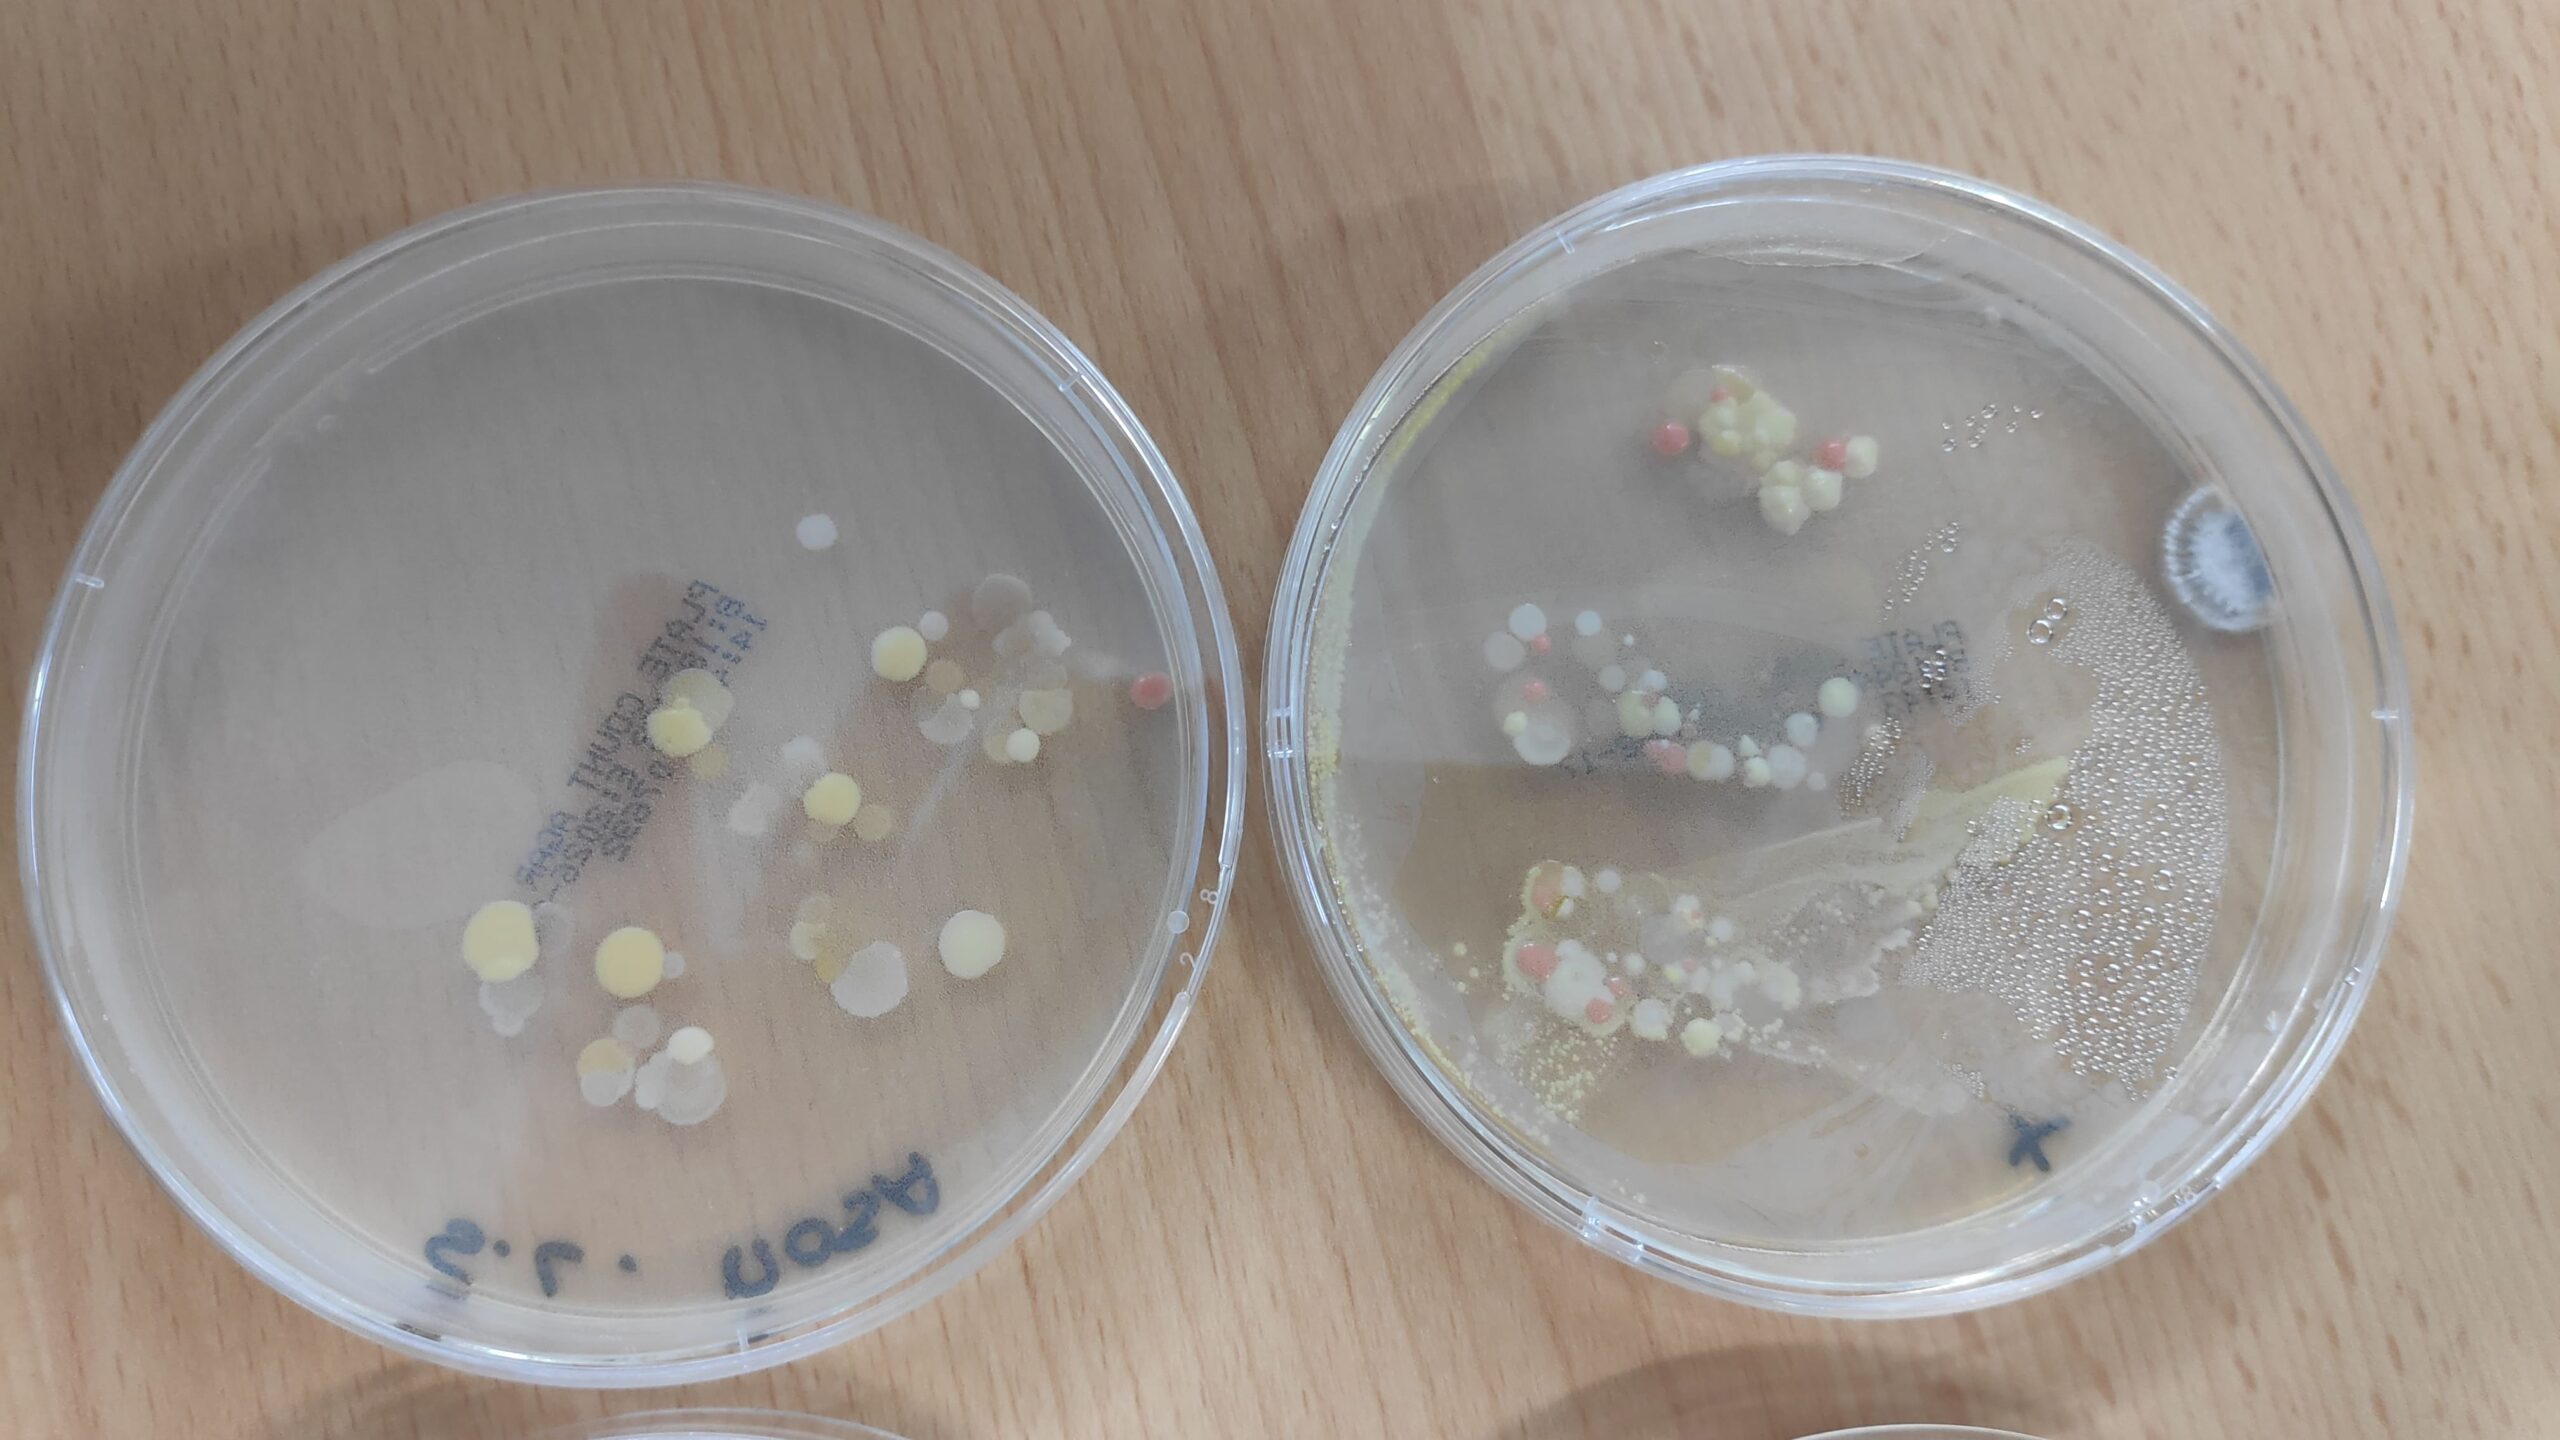
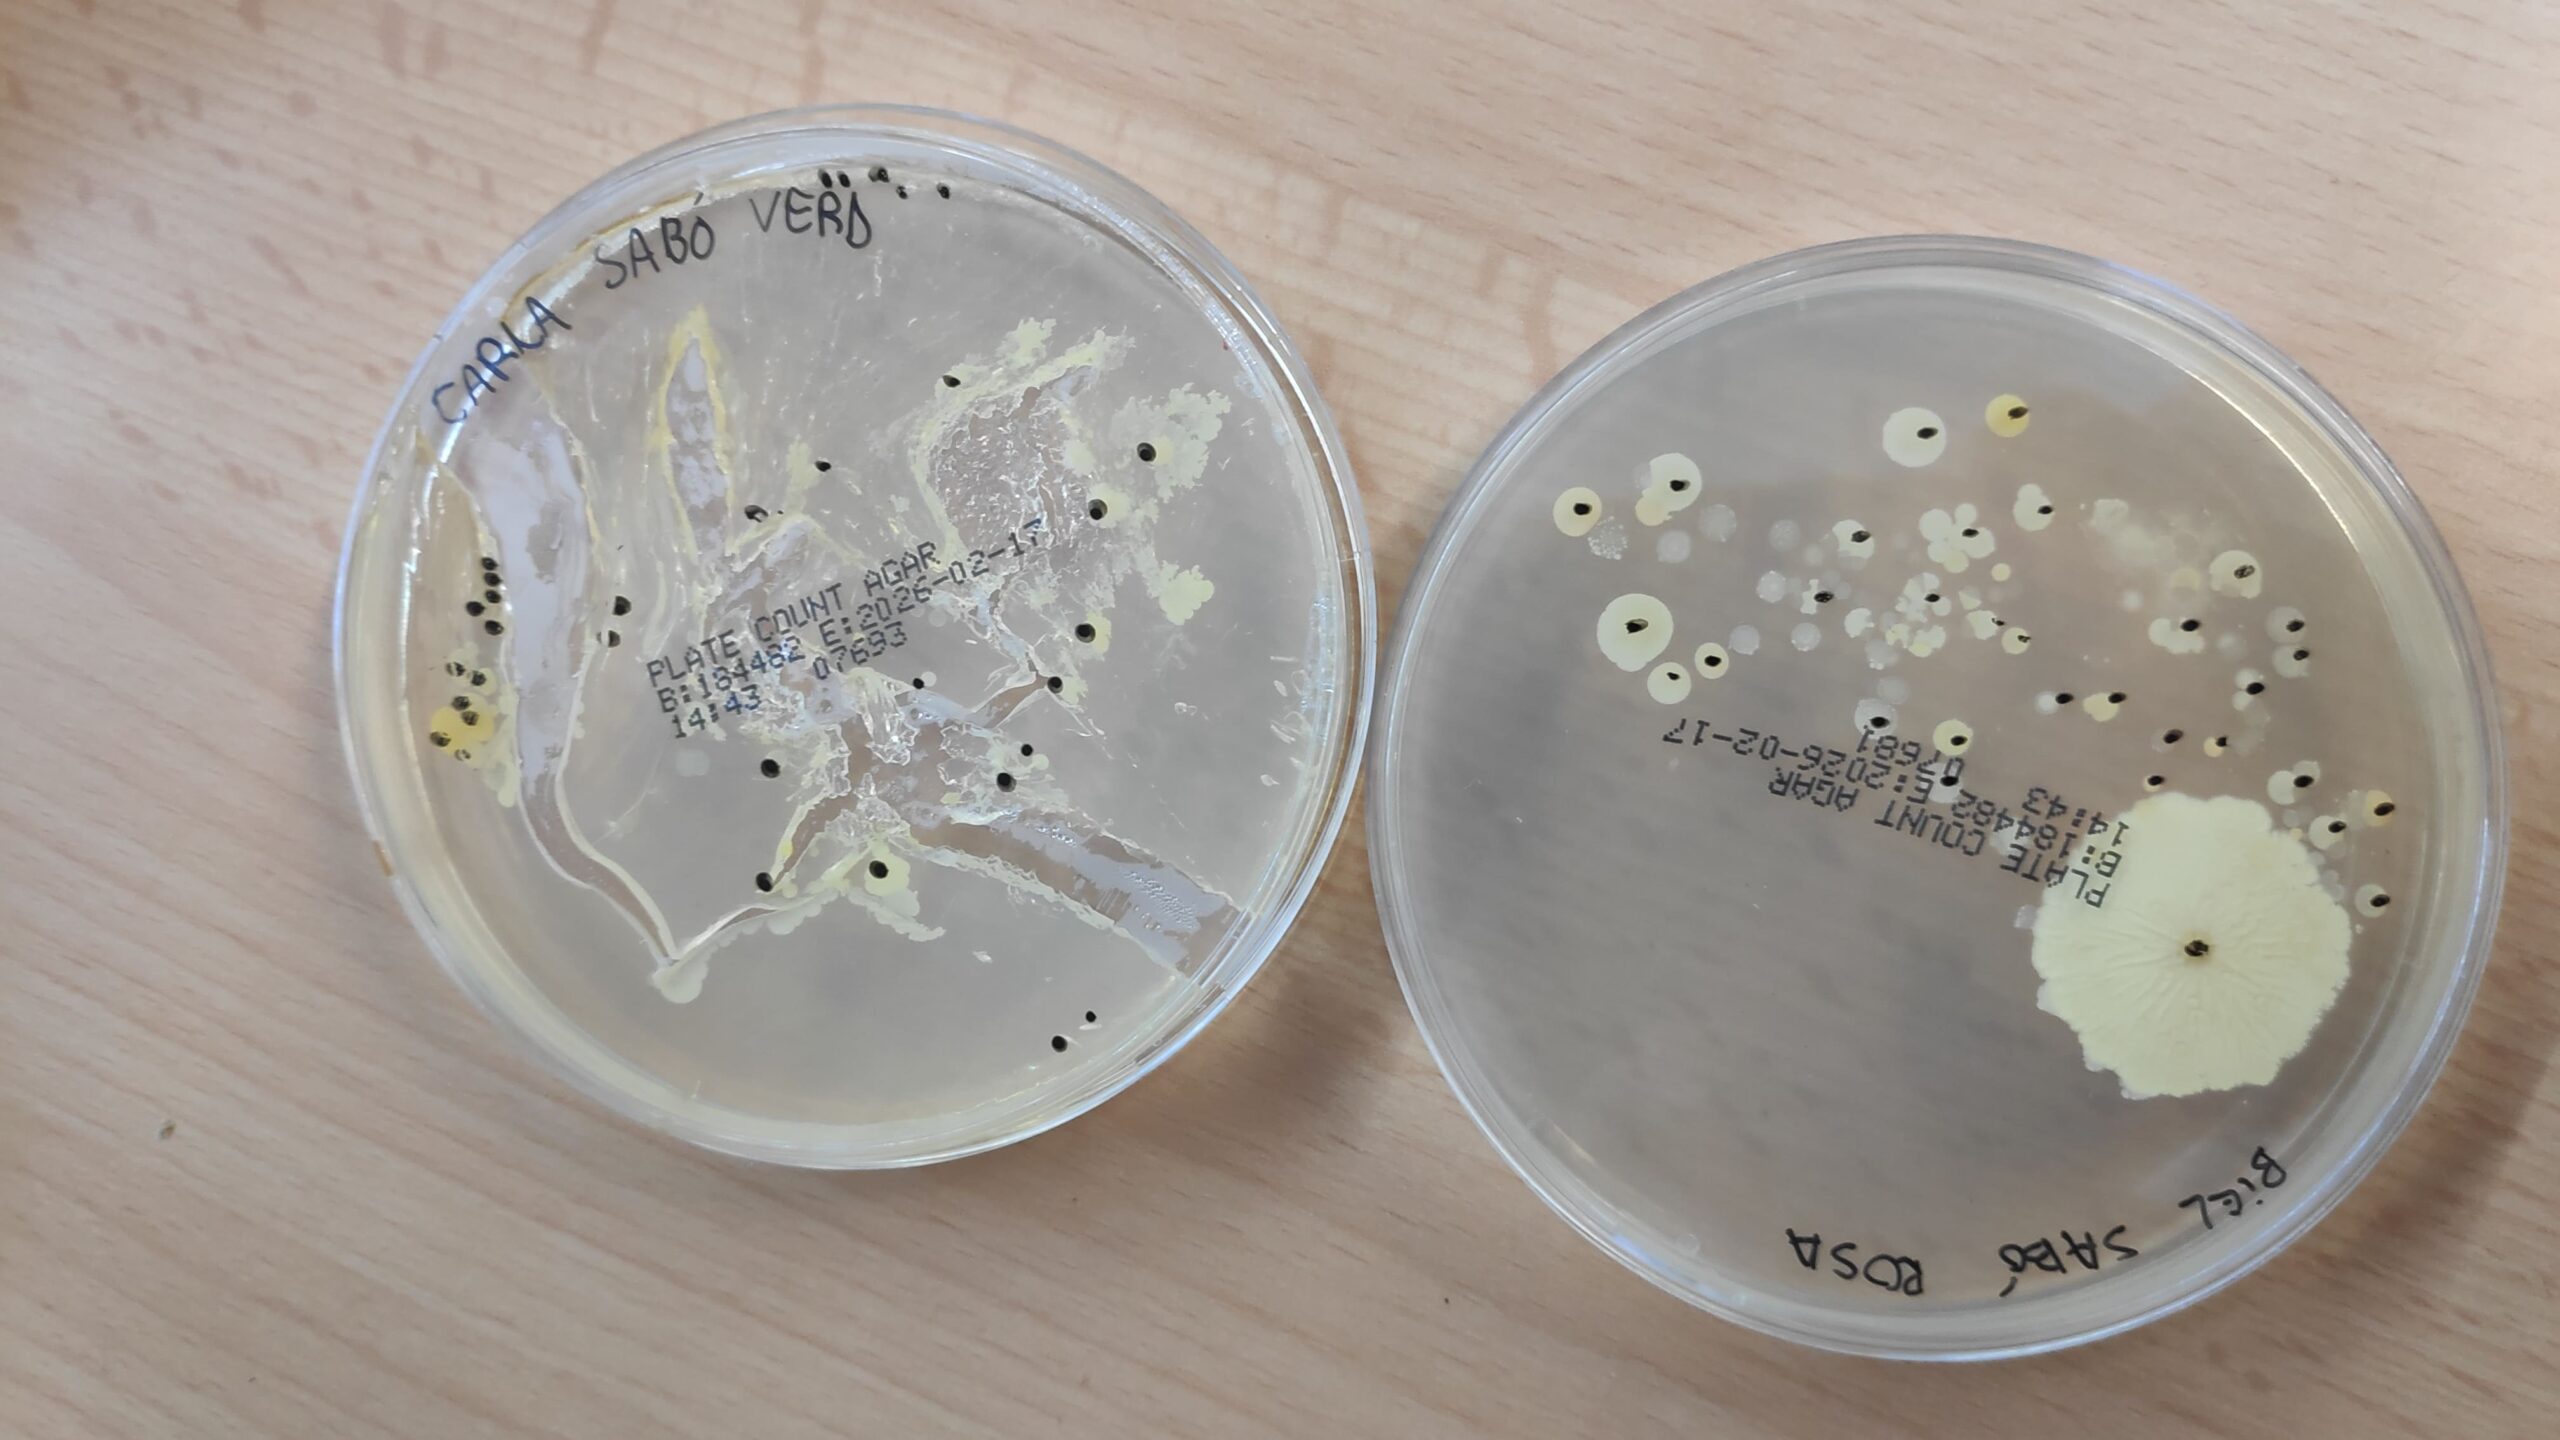

A l’optativa de primer de batxillerat “Reptes de Biologia i Geologia” hem estat practicant el disseny experimental (que molts faran servir al seu treball de recerca). En aquesta activitat hem investigat:
- Quin és el millor sabó “matabacteris”? i hem treballat al laboratori després d’haver dissenyat els passos a realitzar i les variables a estudiar i a controlar.
Com podeu veure a les imatges de les plaques de cultiu , encara no hem resolt aquest problema!!